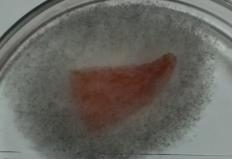
C:\Users\���������\Documents\�����������\�����, ������� �������\P_20150127_192416.jpg

ВЛИЯНИЕ
ЭЛЕКТРОСТАТИЧЕСКОГО ПОЛЯ НА СОХРАННОСТЬ СПЕЛЫХ ТОМАТОВ
Кузнецов А.Л., Будаева В.А.
Московский государственный университет
пищевых производств (ФГБОУ ВПО «МГУПП»)
В представленной статье приведены данные по
изучению влияния электростатического поля на сохранность спелых томатов.
Показана возможность уменьшения потерь влаги из томатов на 40% по сравнению с
образцами без обработки. Проведено сравнение потерь веса томатов с
повреждениями и без, при разных температурных режимах хранения. Установлено
замедление процессов порчи повреждённых томатов после обработки в
электростатическом поле.
Ключевые слова: электростатическое поле, обработка и сохранность
плодоовощных культур, потеря влаги.
I. Введение
Одной из актуальных проблем сельскохозяйственной
отрасли является сохранение
плодоовощной продукции. С момента уборки урожая с полей до процесса переработки
происходят наибольшие качественные и количественные потери. В большей степени,
вызванные нестабильностью температурных режимов хранения и микробиологической
загрязнённостью сырья. Как правило, в
послеуборочный период овощи попадают в неблагоприятные условия: повышенные
температуры, более 200С (при оптимальных 13-210С для
зелёных томатов и 8-100С для розовых и красных) и низкая влажность
воздуха 35-65% (при оптимальной 80-90%). Потери массы томатов варьируются, в
зависимости от множества факторов: от степени зрелости плодов, от сорта,
времени года, температурного режима хранилища и сроков хранения. Известно, что
с течением времени потери влаги, постепенно снижаются, но плоды постепенно
теряют товарный вид (сморщиваются), а если были поверхностные повреждения, то с
большой вероятностью возможно развитие микрофлоры [1].
Все виды потерь плодоовощных культур можно
разделить по стадиям: сбор урожая (механизированный или ручной),
транспортировка на сортировочный пункт, сортировка и укладка в тару,
транспортировка к месту хранения до востребования, хранение и транспортировка
потребителю/ на переработку. Суммарные потери веса томатов могут достигать 10%
на пути поле-хранилище, большая часть потерь связана с повреждением кожуры, что
приводит к интенсивным процессам порчи. Из-за незначительных повреждений:
трещин, проколов, помятостей процесс порчи ускоряется, особенно у крупных
плодов.
Большая часть плодов поступает в хранилища на
дозревание с применением этилена (из расчёта 10-20 л на 1 т плодов), но часть
плодов собирается дозревшими, что делает их наиболее уязвимыми к повреждениям.
Для длительного хранения томаты должны быть
плотными, с плотной кожицей и высоким содержанием сухого вещества. Зрелые плоды
томата сохраняются до 1,5 месяцев при температуре 1–3°C без потери качества.
При хранении из плодов испаряется влага, начинают протекать микробиологические
процессы, приводящие к гниению. Одновременно появляется плесень. Поэтому
помещение регулярно проветривается. В таких условиях плоды сохраняются до 3
месяцев. Для увеличения срока хранения рекомендуется покрывать поверхность
плодов вазелином, парафином и другими веществами [1].
Одним из приоритетных, на сегодняшний день,
направлений является разработка систем процессов и машин для перерабатывающих
отраслей АПК, в том числе с использованием нетрадиционных методов обработки
биологического сырья [2]. К таким методам относится и обработка в
электростатическом поле (ЭСП). Ранее [3,4,5], было выявлено воздействие ЭСП на
водные растворы, как простого, так и сложного состава. Были найдены методики
интенсификации и замедления биохимических процессов в зависимости от времени
обработки, напряжённости и температуры среды.
II. Постановка задачи
Цель исследований состояла в изучении
возможности замедления процессов гниения за счет предварительной обработки
плодов томатов в электростатическом поле. Определение параметров обработки для
спелых целых и повреждённых плодов томатов.
Для данных исследований была собрана
лабораторная установка, включающая: высоковольтный источник постоянного тока и
камеру с электродами для обработки плодоовощной продукции. В ходе эксперимента
изучались важнейшие параметры обработки в зависимости от первоначального
состояния плодов. Эксперимент проводился в нескольких температурных режимах,
для имитации различных технологических этапов пути томатов, от снятия урожая до
переработки.
Ввиду большого многообразия сортов томатов, были
выбраны сорта подходящие для консервирования и соления с массой плодов 50-70
гр. Все томаты были разделены на четыре группы: контрольные целые и
повреждённые, обработанные целые и повреждённые. В ходе эксперимента целые и
повреждённые томаты помещались в камеру для обработки, при этом изменялось
время обработки, напряжённость поля, затем плоды помещали в камеры с различными
температурными режимами. Через 2-5 суток проводилось изъятие плодов, взвешивание
и определение потери влаги, наличие микробиологической порчи на поверхности
плодов. И сравнение с контрольной группой.
III. Результаты и
обсуждения
На первом этапе исследований необходимо было
зафиксировать произвольную величину
напряженности электростатического поля и изменять только величину времени
пребывания томатной массы в межэлектродном пространстве. Была выбрана
достаточно высокая величина напряженности поля
![]() =74,1 кВ/м, чтобы
определить принципиальную возможность данной технологии. Рассматривался вариант, который
характеризовал бы нахождение томатов либо в хранилище, либо в ангаре при температуре Т=180С.
Полученные результаты представлены на рис. 1.
=74,1 кВ/м, чтобы
определить принципиальную возможность данной технологии. Рассматривался вариант, который
характеризовал бы нахождение томатов либо в хранилище, либо в ангаре при температуре Т=180С.
Полученные результаты представлены на рис. 1.

Рисунок 1. Влияние времени ЭСО на потерю массы поврежденных томатов
Анализ полученной зависимости позволяет сделать
вывод о том, что воздействие электростатического поля тормозит процесс
испарения воды из порезов и микротрещин томатов. Если за три дня из контрольной
массы томатов потеря составила до 92% влаги, то из томатов, обработанных в
электростатическом поле, испарилось около 50% при времени обработки 220-240 с.
Дальнейшее увеличение времени пребывания томатов в ЭСП не снижает потерю влаги.
Следовательно, можно сделать общий вывод о том, что энергия электростатического
поля влияет на процесс испарения воды из объема плодов томатов при определенном
времени обработки в электростатическом поле.
Для увеличения срока сохранности томатов в
хранилищах могут поддерживать температуру от 20С до 50С.
Поэтому были проведены исследования в этом интервале температур при разных
значениях напряженности величины электростатического поля (рис. 2).

Рисунок
2. Зависимость потери массы поврежденных томатов при разных температурах
хранения
Полученные результаты показали, что при низких
температурах электростатическая обработка (ЭСО) практически не позволяет
получать существенный эффект по снижению потери массы продукта даже при высоких
напряженностях электростатического поля.
В летний период при транспортировке томатов
также происходит потеря суммарной массы томатов. Для сравнения температурного
воздействия на процесс испарения воды из томатов была выбрана максимальная
температура Т=320С (рис. 3).

1, 2 – зависимости влияния ЭСО на потерю массы
3 –
математическая зависимость процесса потери массы томатов для интервала
температур 180С Т 320С
Время
нахождения томатов в электростатическом поле τ= 30 с.
Рисунок
3. Зависимость потери массы у поврежденных томатов при транспортировке
Математическая обработка полученных результатов
позволила получить усредненную величину потери воды томатами при
транспортировке и хранении после предварительной электростатической обработке в
летний период с интервалом температур
180С Т 320С, которая составила около 65% при 90%
потери для необработанной продукции в электростатическом поле.
Таким образом, для данного интервала температур
обработка в течение 30 с и напряженности поля ![]() = 35кВ/м является
достаточной, чтобы в течение 3 дней сохранять продукцию с поврежденной
поверхностью плода.
= 35кВ/м является
достаточной, чтобы в течение 3 дней сохранять продукцию с поврежденной
поверхностью плода.
Учитывая, что в хранилище либо на переработку
поступает большой объем продукции и использование данной технологии потребует
достаточно большой интенсивности разгрузочных работ, необходимо было установить
возможность снижение времени электростатической обработки и напряженности ЭСП
(рис. 4). Полученные результаты показали, что при времени обработки ![]() =30с оптимальный интервал напряженности для температур 18
=30с оптимальный интервал напряженности для температур 18![]() Т32
Т32 ![]() составляет 25-30
кВ/м.
составляет 25-30
кВ/м.

Рисунок
4. Влияние напряженности ЭСП на потерю массы поврежденных томатов
Полученные ранее результаты [4,5]показали, что
температура имеет колоссальное значение для процессов протекающих при
электростатической обработке и для возможностей использования технологии. Было
выявлено что в интервале температур 15![]() Т50
Т50 ![]() (рис. 5) система
наиболее восприимчива к ЭСО, при меньших температурах эффект от обработки
незначителен, что было подтверждено при изучении потери массы поврежденных
томатов (рис. 2). Так как томаты более чем на 90% состоят из воды данные
результаты можно считать сопоставимыми.
(рис. 5) система
наиболее восприимчива к ЭСО, при меньших температурах эффект от обработки
незначителен, что было подтверждено при изучении потери массы поврежденных
томатов (рис. 2). Так как томаты более чем на 90% состоят из воды данные
результаты можно считать сопоставимыми.

Рисунок
5. Влияние температуры воды на объём выделившейся газовой фазы под действием
электростатического поля (закрытая система)
В сравнении с повреждёнными томатами,
целые томаты значительно лучше удерживают влагу. Анализ полученной зависимости
(рис. 6) показал, что с увеличением температуры хранения потери влаги
увеличиваются, при этом ЭСО не оказывает значительного воздействия на этот
процесс. Скорее всего, это связано с целостностью оболочки (кожуры), которая
являясь мембраной, принимает на себя большую часть энергии поля. В случаи,
когда кожура имеет разрыв, и структура нарушена, начинаются процессы отмирания
тканей с потерей влаги, на которую в данном случаи и воздействует ЭСП. Стоит
отметить, что избыточная напряженность ЭСП обладает обеззараживающими
свойствами, подавляя рост микроорганизмов, но этот аспект требует
дополнительных исследований.

Рисунок
6. Влияние напряженности ЭСП на потерю массы целых томатов
|
|
|
Рисунок
7. Сравнение влияния ЭСП, левый томат без обработки, правый томат после
обработки ЭСП через 3 суток при Т=32![]()
Визуальная оценка результатов обработки (рис. 7)
показала, что в большинстве случаев обработка оказывает благотворное
воздействие, сохраняется внешний вид, тормозится рост микроорганизмов,
уменьшаются потери влаги. Но в ряде случаев, при некоторых низких
напряжённостях ЭСП, обработка дала обратный эффект, стимулируя рост
микроорганизмов. Данный эффект был ожидаем, так как известно, что
микроорганизмы по разному воспринимают воздействие различных электро-физических
воздействий и как только часть микроорганизмов погибает их место сразу занимают
«выжившие» микроорганизмы, которые благодаря активному делению быстро занимают
свободную поверхность.
IV. Выводы
Показано, что воздействие ЭСП на спелые томаты
зависит от их целостности и температурного режима хранения. Научная новизна
данной технологии заключается в использовании нетрадиционных методов обработки
биологического сырья, без использования парафинов и других веществ, для
продления сроков хранения.
Показано, что электростатическая обработка
позволяет уменьшить потерю влаги из томатов на 40% по сравнению с контрольной
системой без обработки ЭСП.
Установлено, что при времени нахождения томатов
220-250с в электростатическом поле ![]() = 71,4 кВ/м при температуре Т= 180С за три дня
хранения не наблюдается появление плесени в местах повреждения.
= 71,4 кВ/м при температуре Т= 180С за три дня
хранения не наблюдается появление плесени в местах повреждения.
Для интервала температур 180С Т 320С
обработка в течение 30 с и напряженности поля ![]() = 35кВ/м является
достаточной, чтобы в течение 3 дней сохранять продукцию с поврежденной
поверхностью плода.
= 35кВ/м является
достаточной, чтобы в течение 3 дней сохранять продукцию с поврежденной
поверхностью плода.
В дальнейшем планируется изучить влияние ЭСП на
другие плодоовощные культуры с целью продления сроков хранения, повышения
безопасности продуктов за счёт отказа от использования химических составов для
защиты от порчи.
Список
литературы
1. Товароведение и экспертиза продовольственных
товаров: Учебник / Под. ред. проф. Елисеевой Л.Г. – М: 2006. 800с.
2. Галкин Ю.А. Разработка плазменных
электромагнитных устройств для увеличения сроков хранения плодовоовощной
продукции. Отчет ГНУ ВИЭСХ, 2011.
3. Кузнецов, А.Л. Электростатическая обработка
жидких сред подавления роста микроорганизмов /
А.Л. Кузнецов, Л.О. Никифорова
// Сборник материалов VI межведомственной
научно-практической конференции «Товароведение, общественное питание и
технологии хранения продовольственных товаров»- Москва, 2014. – С. 109-112.
4. Л.А. Чурмасова, Л.О. Никифорова, А.Л.
Кузнецов ВЛИЯНИЕ ЭЛЕКТРОСТАТИЧЕСКОГО ПОЛЯ НА ДИСТИЛЛИРОВАННУЮ ВОДУ //
Химическая технология - 2014.- №5.
5. Л.О. Никифорова, А.Л. Кузнецов, А.Ю.
Никифоров, С.Р. Муссе, В.А. Будаева ИССЛЕДОВАНИЕ ВОЗДЕЙСТВИЯ
ЭЛЕКТРОСТАТИЧЕСКОГО ПОЛЯ НА ВОДНЫЕ РАСТВОРЫ, СОДЕРЖАЩИЕ СУЛЬФФАТЫ И ХЛОРИДЫ
ТЯЖЕЛЫХ МЕТАЛЛОВ // Химическая
технология - 2014.- №11.